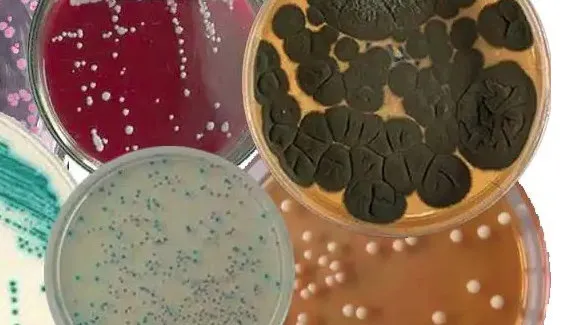
常用细菌培养基

细菌培养基分类、选用指南及实验室必备清单
发布时间:2026-03-10 浏览次数:35
培养基是细菌培养与微生物研究的核心载体,其成分设计、功能定位直接决定细菌培养的成败,也影响后续实验结果的准确性与可靠性。依据营养组成、使用用途及物理状态,细菌培养基可划分为不同功能类型,而在科研与临床实操中,各类培养基又依使用频率、应用场景形成了清晰的梯队划分。精准掌握不同培养基的特性、适用范围及选择逻辑,是微生物科研工作的基础要求。
一、按功能划分:五大核心培养基类型
1. 基础培养基
作为细菌培养的基底,含细菌生长繁殖所需的碳源、氮源、无机盐等基本营养,可满足多数非苛养菌的生长需求,也是配制各类特殊培养基的基础原料。经典的普通肉汤培养基是液体形态,多用于细菌增菌培养;添加琼脂制成的琼脂平板培养基为固体形态,是细菌分离、纯化与菌落特征观察的基础工具。
2. 营养培养基
在基础培养基基础上添加血液、血清、酵母浸膏等特殊营养成分,专门满足营养要求较高的苛养菌生长需求。血琼脂平板能有效促进肺炎链球菌、淋病奈瑟菌等苛养菌繁殖,还可通过观察溶血现象辅助细菌鉴别;巧克力琼脂平板经加热处理释放红细胞内的特殊营养因子,是嗜血杆菌属的专属培养载体。
3. 选择培养基
核心设计逻辑为 “抑杂留标”,利用不同细菌的生理特性差异,在培养基中添加特定化学物质抑制非目标细菌生长,为目标菌营造专属生长环境,实现目标菌的富集与分离。这类培养基是肠道菌、弧菌等特定菌群研究的关键工具,能大幅减少杂菌干扰,提升目标菌分离效率。
4. 鉴别培养基
以细菌代谢特性为核心鉴别依据,添加特定底物与指示剂,细菌生长后会因代谢产物不同,呈现出颜色、形态的差异化特征,可直接通过培养结果初步判断细菌种类,无需额外生化试验,大幅提升细菌鉴定效率,是肠道杆菌等菌群生化鉴定的核心载体。
5. 厌氧培养基
专为厌氧菌培养设计,核心是通过添加还原剂降低培养基氧化还原电势,营造无氧的生长环境,解决厌氧菌在有氧环境中无法生长的技术难题。硫乙醇酸盐液体培养基多用于厌氧菌增菌培养,疱肉培养基为固体形态,是破伤风梭菌、产气荚膜梭菌等厌氧菌的常用培养工具。

二、第一梯队:实验室 / 临床超高频率必备
这类培养基是科研与临床实验室的刚需品类,覆盖通用培养、分离纯化、生化鉴定等基础且高频的实验需求,适配绝大多数细菌研究场景,是微生物实验的 “基础盘”。
LB 培养基:分子生物学、基因工程首选通用培养基,可快速培养绝大多数革兰氏阳性、阴性菌;
营养肉汤 / 营养琼脂:基础培养基经典代表,液体肉汤用于细菌增菌、菌种保存,固体琼脂用于非苛养菌的分离、纯化与计数;
胰蛋白胨大豆肉汤 / 琼脂:营养丰富,支持多种细菌及部分苛养菌生长,分别用于细菌增菌、药敏试验和菌落形态观察;
血液琼脂培养基:兼具营养与鉴别功能,培养高营养需求病原菌,同时通过溶血现象辅助菌种判断;
麦康凯平板 / 伊红美蓝琼脂:肠道菌研究必备,兼具选择与鉴别特性,快速区分乳糖发酵菌与非发酵菌,筛选大肠埃希氏菌与肠道致病菌;
三糖铁琼脂:肠杆菌科细菌生化鉴定核心,通过糖发酵与硫化氢产生情况完成肠道杆菌初步鉴别;
半固体琼脂培养基:专门用于观察细菌动力,也可实现菌种短期保存,操作简便、结果直观。

三、第二梯队:高频率专项检测 / 特殊菌培养
聚焦专项检测与特殊菌培养,使用频率较高,是解决特定研究问题的 “专用工具”,适配苛养菌、厌氧菌、弧菌等特殊菌群及大肠菌群检测等专项实验。
苛养菌培养:巧克力平板适配脑膜炎奈瑟菌、流感嗜血杆菌,脑心浸液培养基满足各类高营养要求细菌及厌氧菌初步培养;
肠道致病菌分离:SS 琼脂、木糖赖氨酸脱氧胆酸盐琼脂高效抑制杂菌,富集沙门氏菌、志贺氏菌;
特殊菌鉴别 / 培养:甘露醇盐琼脂分离鉴别金黄色葡萄球菌,碱性蛋白胨水、TCBS 培养基针对弧菌耐碱特性,实现霍乱弧菌、副溶血弧菌的增菌与分离;
生化特性鉴定:尿素培养基检测尿素酶活性,柠檬酸盐培养基检测柠檬酸盐利用能力;
专项检测:庖肉培养基为厌氧菌经典固体培养基,乳糖胆盐发酵管 + 煌绿乳糖胆盐肉汤形成大肠菌群 “初筛 - 确证” 体系,适配食品、饮用水微生物检测。

四、第三、四梯队:中低频率特殊场景适用
这类培养基针对特殊生化鉴定、少见菌培养及小众研究场景设计,使用频率依研究需求而定,是微生物研究中 “补位型” 工具,精准适配细分研究方向。
1. 第三梯队:中频率,特殊生化鉴定 / 少见菌培养
核心适配结核分枝杆菌、白喉杆菌等特殊菌种及精细化生化试验。罗氏培养基为结核分枝杆菌专用,因菌株生长缓慢,培养周期可达 4-8 周;卵黄琼脂、醋酸铅培养基分别检测细菌卵磷脂酶、硫化氢产生特性;6.5% 氯化钠肉汤通过耐盐性鉴别肠球菌与其他链球菌;中国蓝平板作为麦康凯平板替代选择,辅助肠道菌筛选。
2. 第四梯队:低频率,专用 / 小众场景
专为放线菌、真菌、酵母菌等特殊微生物及部分传统实验设计。高氏一号培养基是放线菌分离鉴定专用载体;马铃薯葡萄糖琼脂、YM 培养基主要用于真菌与酵母菌培养,也适配部分土壤细菌;改良罗氏培养基优化结核分枝杆菌培养效率,远藤氏培养基为水中大肠菌群检测专用;蛋白胨水、肉膏汤培养基虽使用频率降低,但在靛基质试验、传统微生物实验中仍有应用。

五、核心选择原则:精准匹配,科学选用
培养基的选择直接影响实验结果,核心需围绕研究目标、细菌特性、实验目的三大维度展开,兼顾实操性与准确性:
匹配细菌类型:苛养菌优先选血琼脂、巧克力平板等营养丰富的培养基,厌氧菌选用专用厌氧培养基,结核分枝杆菌、弧菌等特殊菌种匹配其专属培养基;
贴合实验目的:增菌培养选液体培养基,分离纯化、菌落观察选固体琼脂培养基,生化鉴定选对应鉴别培养基,专项检测需搭配专属选择 / 鉴别培养基组合;
把控实验规范:严格遵循培养基配制、灭菌流程,把控培养基质量,避免杂菌污染,确保实验结果的可靠性。
本文由环凯转载自“医研学者”公众号,版权归原作者所有,仅供学习参考,如有侵权请联系删除!
